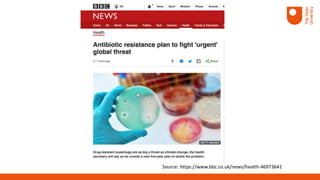
Source: https://www.bbc.co.uk/news/health-46973641

The document discusses the UK's aid program aimed at strengthening capacity for antimicrobial resistance (AMR) surveillance in low and middle-income countries (LMICs). It outlines the objectives of a multi-phase approach to improve AMR data collection, sharing, and professional training while addressing systemic challenges within these countries. Key recommendations highlight the importance of collaboration among health professionals, effective laboratory practices, and targeted learning to tackle the complexities of AMR effectively.

![“And that’s [One Health] been a big thing, again for our own team [Fleming
Fund / Management Agency] to understand, and then for countries to
understand. Because everybody from WHO, and the tripartite, DH, Mott,
and to some extent on the ground uses the words One Health, and
understands that One Health is important for antibiotic resistance, but
without really understanding how to achieve that” [AMR Community /
Expert, P23]
2. AMR is a multi-disease and multi-sectoral challenge](https://image.slidesharecdn.com/earli19presentation13aug19charitonoslittlejohn-190813063515/85/Earli19-presentation-13-aug19_charitonos_littlejohn-12-320.jpg)
![“most of the procurement agency in countries base their choice of reagent based on
cost. And so, they will select re-agents that are unfit to provide good quality testing.
And this is because there is a disconnection between the finance ministry and the
technical people, even from the country. And so, these systemic issues like quality is not
restricted to train lab technicians, to do good testing. They know that they need good
reagents, but they don't have these reagents, because the national procurement
agency is not supporting [purchase of] this reagent because they cost too much
initially…And there is all this economic value chain that is not taken into consideration
by the finance ministry" (P5)
3. AMR Surveillance is an outcome of well-functioning
lab networks](https://image.slidesharecdn.com/earli19presentation13aug19charitonoslittlejohn-190813063515/85/Earli19-presentation-13-aug19_charitonos_littlejohn-13-320.jpg)
![4. AMR Surveillance relies on Good Practice
“…you know, antibiotic prescribing was a very easy task when I
was a young physician because we had a lot of antibiotics and
every antibiotic was working on most bacteria. So, it was very
easy. Now it's very, very complicated in many instances,
because we have bacteria on which very few antibiotics which
are working. And depending on the patient, you have strictly to
use this one or this one, at that dose or this dose. And very
often, it's a great help for the clinicians to have the advice of
the microbiologist to choose the right antibiotic […]” [AMR
Community / Experts, P18]](https://image.slidesharecdn.com/earli19presentation13aug19charitonoslittlejohn-190813063515/85/Earli19-presentation-13-aug19_charitonos_littlejohn-14-320.jpg)
![“The first one is to report it to the clinician and tell him, well, you have to use antibiotic
X or Y and not antibiotic Z to treat your patient…The second use is to tell a clinician
every year, during the past year, we have isolated, I don't know, 564 bacteria of that
type in your department…To give them the statistics. Which will help them to use this
data in what we call an empiric manner… and so you can adapt your empirical
treatment using the retrospective data…. And the third use of the data is to gather all
the information from hospitals or health centres… and to have a global picture in the
country of the susceptibility pattern of each type of bacteria. And so the leaders and
the people that make the public health policy… will take specific measures against
bacteria X” [P18]
5. AMR Surveillance requires data flow across local,
national and global systems](https://image.slidesharecdn.com/earli19presentation13aug19charitonoslittlejohn-190813063515/85/Earli19-presentation-13-aug19_charitonos_littlejohn-15-320.jpg)
![“The second major issue is about trust…If you go to a UK hospital with a suspicion of
infection, immediately, you will be taking a number of samples depending on the type
of infection. And these samples will go to the lab, and the clinicians will use the result
to treat you because they trust the results from the lab. In many, many places in
developing countries, this does not happen because first, the clinician do not do the
sampling. Very often, they do not do the sampling, because… they don't trust the result
of the lab. And if they don't trust the results of the lab, they don't do the test because
they know that they will not use the result…They don't send test, so the lab has very
little tests to perform, and so they are not very good at performing tests and they are
not very good at giving good results. And so it doesn't work” [P18]
6. AMR surveillance requires trust and openness
among professionals](https://image.slidesharecdn.com/earli19presentation13aug19charitonoslittlejohn-190813063515/85/Earli19-presentation-13-aug19_charitonos_littlejohn-16-320.jpg)
![“it all comes back to resourcing: if you are a lab technician working in a poorly
resourced lab…you will still feel undervalued and under-represented…” [P22].
“[difficult to] technically assess precisely the results of the susceptibility…It’s extremely
difficult technically to say bacteria X is susceptible to antibiotic Z, but not to antibiotics
A and B” [P18].
7. AMR surveillance relies on motivated and skilful
professionals](https://image.slidesharecdn.com/earli19presentation13aug19charitonoslittlejohn-190813063515/85/Earli19-presentation-13-aug19_charitonos_littlejohn-17-320.jpg)








